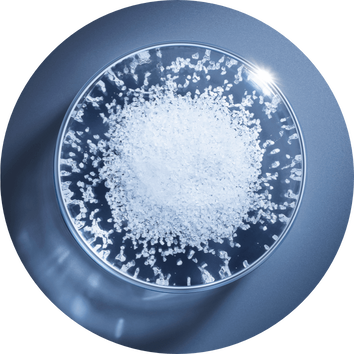

كريم أدفانسد جينيفيك نايت
كريم ليلي يرمّم حاجز البشرة

فوائد المستحضر
ترميم حاجز البشرة ترميماً فائقاً خلال الليل
فمعه، يكشف علم الميكروبيوم الآن عن القوّة الكامنة في ساعات الليل،
وليلة تلو الأخرى، يزداد مظهر البشرة شباباً وصحةً.
- تنعيم البشرة على الفور
- ترميم حاجز البشرة ترميماً فائقاً خلال الليل وحفظ الرطوبة في طبقاتها
- ليلة تلو الأخرى، يزداد مظهر البشرة شباباً وصحةً.
مميّزاته
تمّ تعزيز هذا الكريم بمزيج من المكوّنات النشطة الفعّالة، وأبرزها ملايين سلالات البروبيوتيك والبريبيوتيك، والسيراميدات الثلاثية التي تعزّز حاجز حماية البشرة وحمض الهيالورونيك.
كذلك، يتمتّع بتركيبة طبيعية بنسبة 94%، ومتجددة بنسبة 92%، تمّ تركيزها ليزهو بقوام خفيف يسمح للبشرة بالتنفس، فيما يغلّفها بالكامل ويحافظ على الترطيب والمكوّنات النشطة في داخلها.
ما عليك معرفته أيضاً
تنعيم البشرة على الفور
ترميم حاجز البشرة ترميماً فائقاً خلال الليل وحفظ الرطوبة في طبقاتها
الحفاظ على الرطوبة بنسبة 30% أكثر خلال الليل*
ليلة تلو الأخرى، يزداد مظهر البشرة شباباً وصحةً.
أُثبتت فعاليته سريرياً على أنّه يحسّن البشرة بشكل ملحوظ ودراماتيكي بناءً على 6 مؤشّرات سريرية متعلّقة بشباب البشرة:
نعومة أكثر بـ43%** إشراق أكثر بـ36%** تماسك أكثر بـ35%** امتلاء أكثر بـ33%** خطوط رفيعة أقلّ بـ20%** تجانس لون أكثر بـ22%**
تمّ اختباره من قبل أطباء الجلد على كافة ألوان البشرة وأنواعها، حتّى الحسّاسة منها.
* اختبار أساسي دلالي، 24 امرأة بعد 8 ساعات من الاستخدام
** دراسة سريرية، 82 امرأة بعد 8 أسابيع من الاستخدام
فعالية مُثبتة علمياً
قبل / بعد
كيفية التطبيق
- تُطبّق كمية صغيرة منه بين أطراف الأصابع، وتُفرك لتصبح دافئة.
- يتمّ الضغط باستخدام راحة اليدين على الجبين والخدَّين والذقن.
- تُدلك التركيبة بلطف على البشرة بحركات تتجه من منتصف الوجه نحو أطرافه على الجبين والخدّين والذقن.
- يُختتم التطبيق بضربات طويلة وانسيابية على العنق.
توقيت تطبيقه
يُطبّق الكريم الليلي على البشرة النظيفة كلّ ليلة بعد سيروم أدفانسد جينيفيك الرقم 1 من لانكوم.
نظام العناية بالبشرة الذي تحتاجين إليه
المراجعات (0)
شاركوا رأيكم
دع عملاء لانكوم الآخرين يعرفون ماذا تعتقد
كونوا أول من يكتب مراجعة لهذا المنتج.